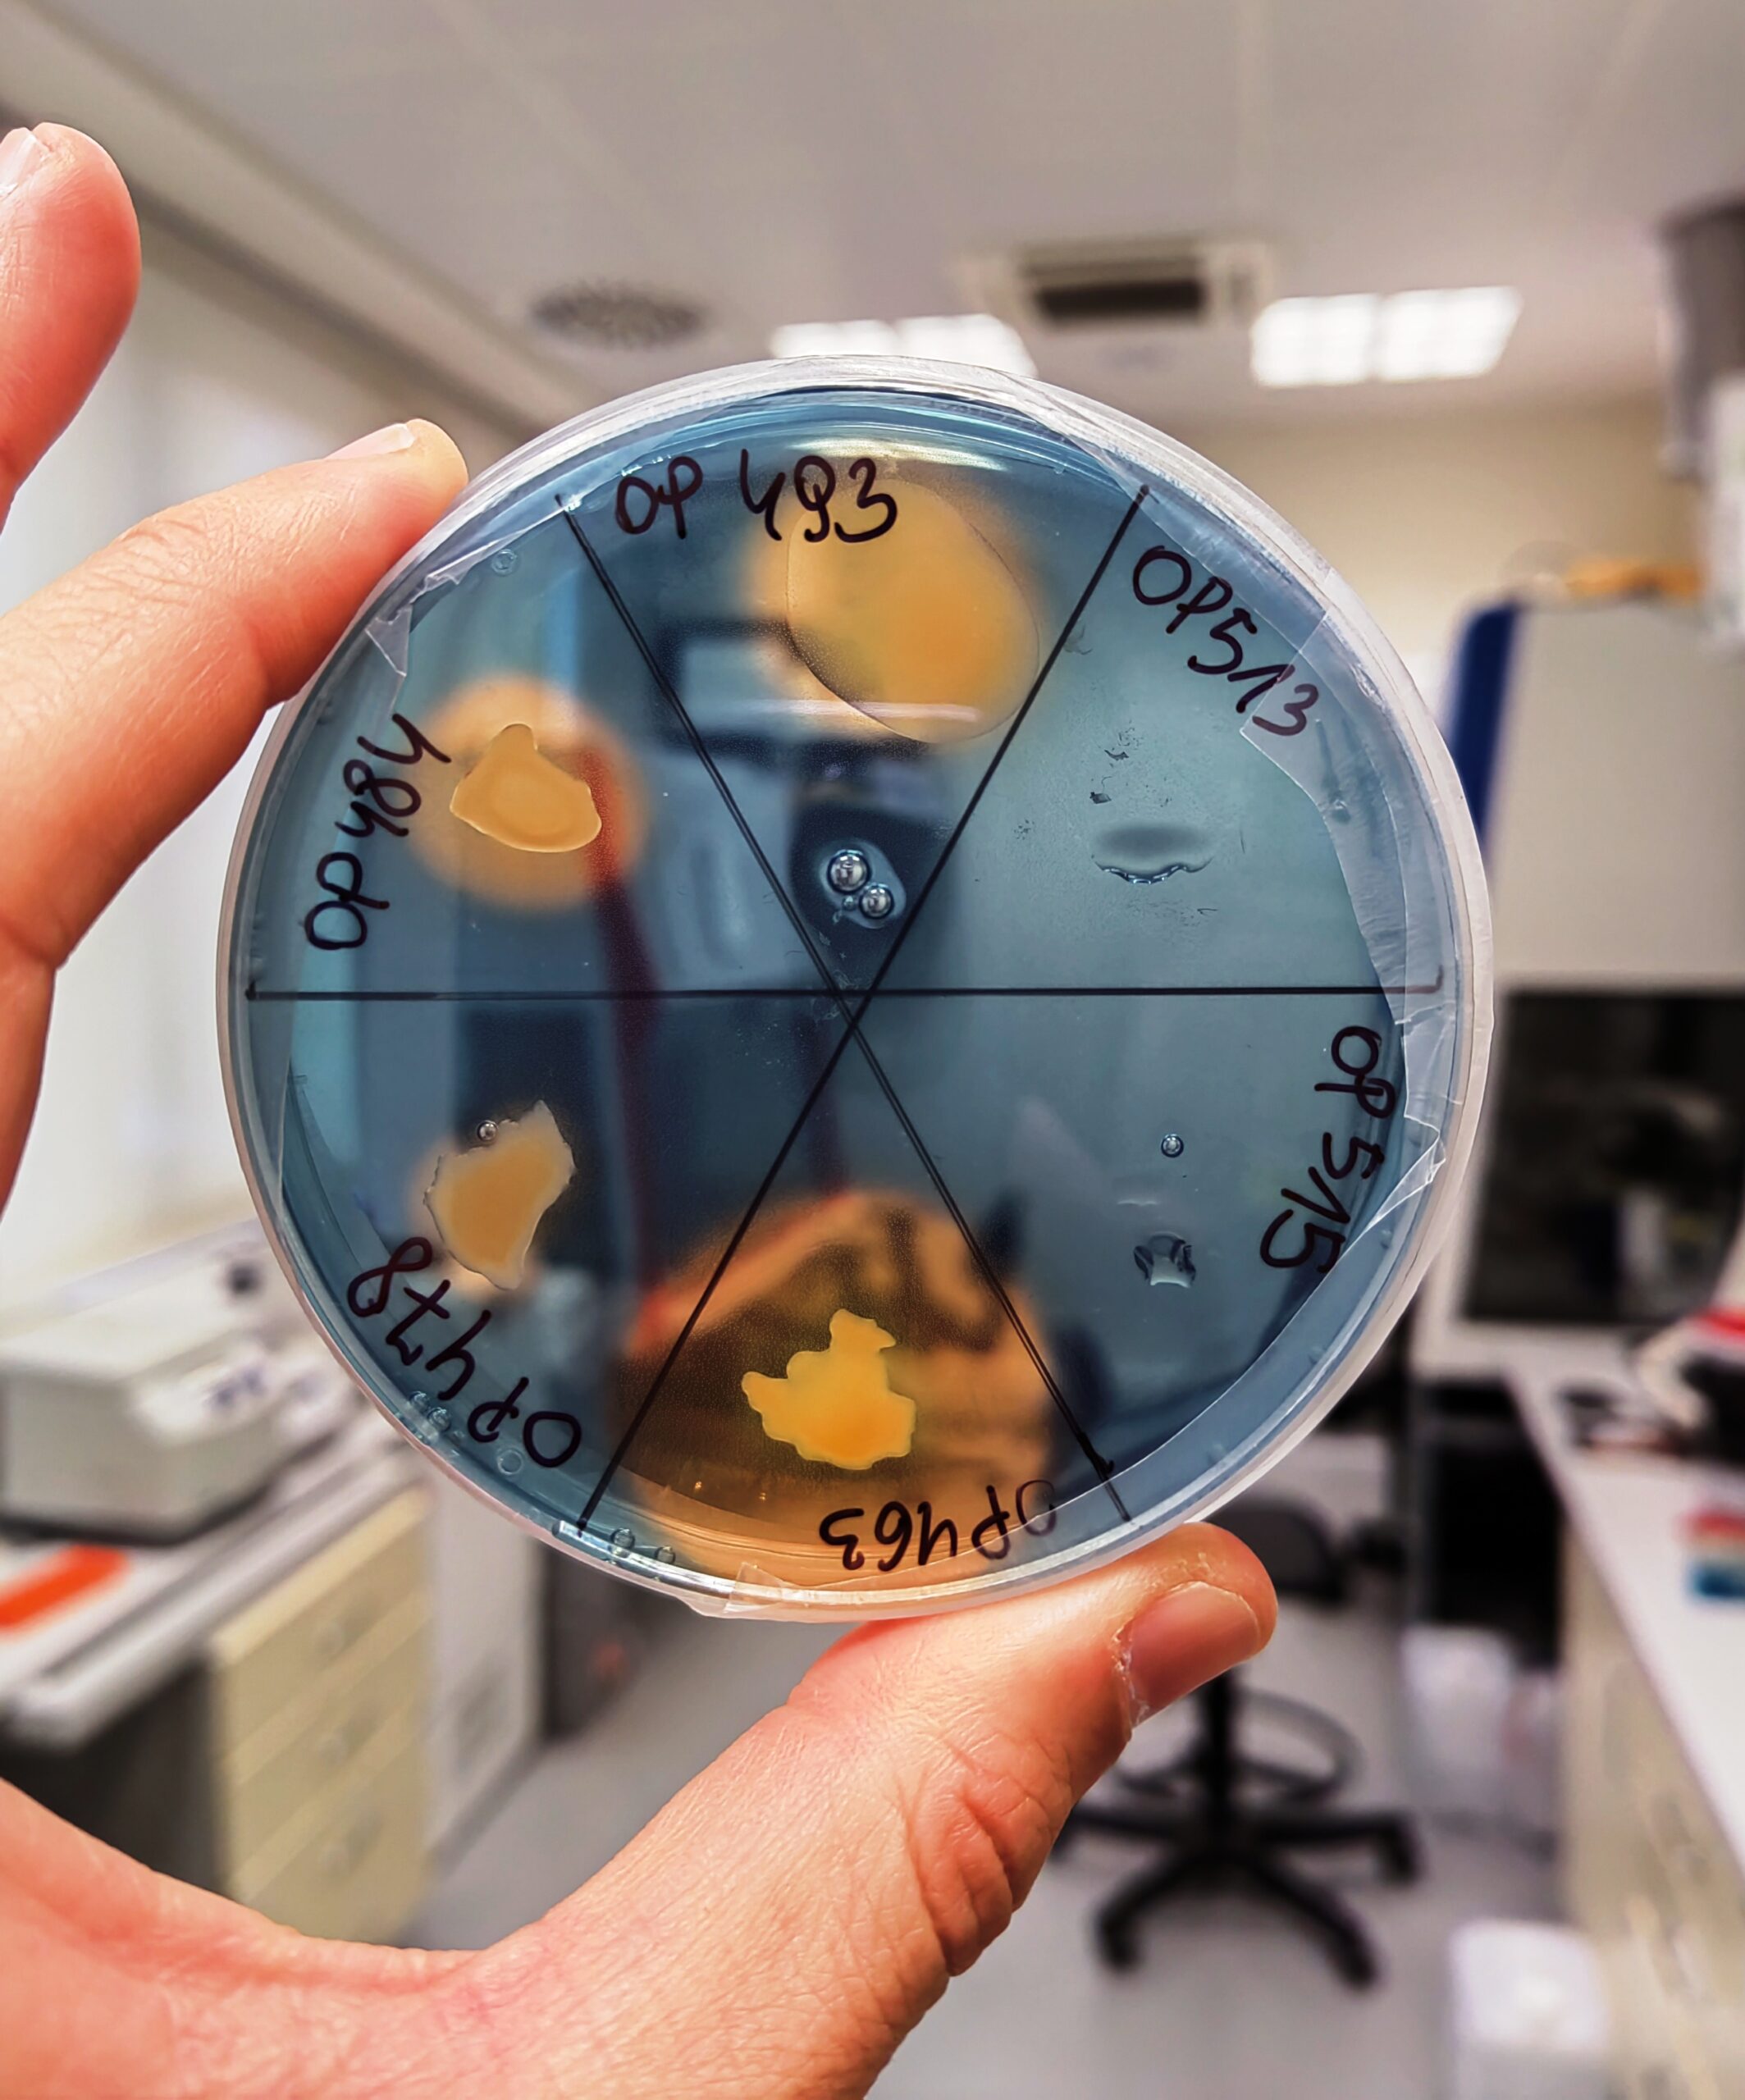

Savjetovanje i inovativna rješenja u biotehnologiji

O nama
BIOINSIGHT, obrt za savjetovanje, osnovan je 2025. s ciljem pružanja informacija, savjeta, znanstvenih uvida i inovativnih rješenja u području biotehnologije i mikrobiologije.
Naše mogućnosti
Pokusi
Osmišljavanje znanstveno utemeljenih pokusa s rezultatima koji će biti ponovljivi i valjani

Analize
Interpretacija rezultata i predlaganje relevantnih analiza

Pametna rješenja
Rješenja za praktični rad u laboratoriju, sukladno pravilima dobre laboratorijske prakse